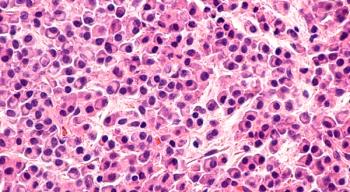

July is UV Safety Awareness Month. See three tips on how to protect yourself from harmful UV rays, which are the leading cause of skin cancer.

Brielle Benyon, Assistant Managing Editor for CURE®, has been with MJH Life Sciences since 2016. She has served as an editor on both CURE and its sister publication, Oncology Nursing News. Brielle is a graduate from The College of New Jersey. Outside of work, she enjoys spending time with family and friends, CrossFit and wishing she had the grace and confidence of her toddler-aged daughter.
Follow Brielle on Twitter @Brielle_Benyon.

July is UV Safety Awareness Month. See three tips on how to protect yourself from harmful UV rays, which are the leading cause of skin cancer.

If passed, the H.R. 2976 bill would defer student loan payments for individuals who are undergoing cancer treatment. Hear what one advocate had to say about it.

The FDA approved Opdivo plus Yervoy to treat a certain subset of patients with metastatic colorectal cancer.

The majority of adolescent and young adult (AYA) patients who are diagnosed with cancer are expected to live past the five-year mark, though survival and health outcomes seem to differ by disease type, according to recent research published in the journal Cancer.

PARP inhibitors have made for new and exciting treatment options for ovarian cancer, but there is still much more work to be done, according to Dennis J. Slamon, M.D., Ph.D.

As the field of lung cancer continues to evolve, here are some of the key discussions patients should have with their health care team, according to one expert.

While having a career as a flight attendant allows individuals to travel the globe, exposure to carcinogens and frequent disruptions in circadian rhythms may increase cancer prevalence in these individuals, according to recent research published in the journal Environmental Health.

Adversity early on in life and increased stress levels could impact ovarian cancer outcomes – even if these instances happen before a woman is diagnosed, according to a recent article published in the journal Cancer.

PARP inhibitors continue to impress in the ovarian cancer space, as findings from the recent phase 3 SOLO-1 trial showed that Lynparza (olaparib) showed clinically-meaningful improvement in progression-free survival (PFS) when used in the first-line maintenance setting.

What are the different types of immunotherapy and, importantly, what are fellow patients saying about them?

The Food and Drug Administration (FDA) has granted a priority review to a new drug application (NDA) for glasdegib to treat patients with previously untreated acute myeloid leukemia (AML) in combination with low-dose cytarabine (LDAC), which is a type of chemotherapy, according to Pfizer, the manufacturer of the drug.

Patients with mantle cell lymphoma (MCL) who were treated with Venclexta (venetoclax) showed a slight improvement in response rates compared with chemoimmunotherapy.

While JAK inhibitors have proven to be an effective treatment for patients with myelofibrosis, a type of myeloproliferative neoplasm (MPN), they may come with a severe downside – in particular, a 16-fold increase in the chance of developing a B-cell lymphoma, according to recent research published in the journal Blood.

Immunotherapy is being tested in the second-line setting for metastatic bladder cancer. Pending trial results, the role of chemotherapy for this patient population may change.

CURE spoke with the chief medical officer of the Leukemia & Lymphoma Society to hear what she thinks are important next steps in improving patient outcomes.

An MPN diagnosis can be overwhelming, but here are some of the basic facts every newly diagnosed patient should know.

We sat down with oncology nurse Christine Stone, M.S.N., RN, OCN, winner of this year's Extraordinary Healer award, to hear about the impact she makes on her patients with cancer.

Dewayne Johnson is the first of hundreds of patients to take Monsanto to trial, claiming that Roundup caused them to get cancer. His case will be seen even sooner than others because in California dying plaintiffs can be given expedited trials.

Age shouldn't be a determining factor in giving a patient with melanoma immunotherapy. In fact, one study found that older patients actually do better on checkpoint blockades.

The Food and Drug Administration approved a combination of Avastin (bevacizumab) plus the chemotherapy agents carboplatin and paclitaxel, followed by Avastin alone, for the treatment of patients with advanced ovarian cancer who have had surgical resection.

The Food and Drug Administration approved Keytruda (pembrolizumab) for the treatment of certain patients with cervical cancer.
The Food and Drug Administration (FDA) approved the supplemental New Drug Application to add to the U.S. Prescribing Information for Kyprolis (carfilzomib) for the treatment of patients with relapsed or refractory multiple myeloma.

The FDA approved the Paxman Scalp Cooling System for patients with solid tumors who wish to prevent chemotherapy-related hair loss.

Although genetic testing could be crucial in developing treatment plans and improving outcomes in women with ovarian and breast cancer, less than 20 percent of eligible patients actually get tested, according to Mike Janicek, M.D.

Using next-generation sequencing (NGS) to test patients with non-small cell lung cancer (NSCLC) for all known genetic mutations associated with the disease appeared to be faster and more cost-effective than testing for one gene at a time – not to mention the results could have treatment implications.

It's time we talk about men's health, says Justin Birckbichler.

Insomnia is a common issue that many patients and survivors face. However, cognitive behavioral therapy and acupuncture was proven to be helpful in a recent study.

NCCN guidelines recommend annual mammograms to detect disease recurrence, but according to the study’s findings, women — even those who had adequate health insurance — were less likely to have their once-a-year mammogram as they became long-term survivors.

Genetic testing is becoming more important in pancreatic cancer, especially since it can point toward more efficacious treatment regimens for some patients.

PD-1 and PD-L1 inhibitors are generally well-tolerated, so most patients face little or no issues with the drugs. However, there are still some things to look out for.